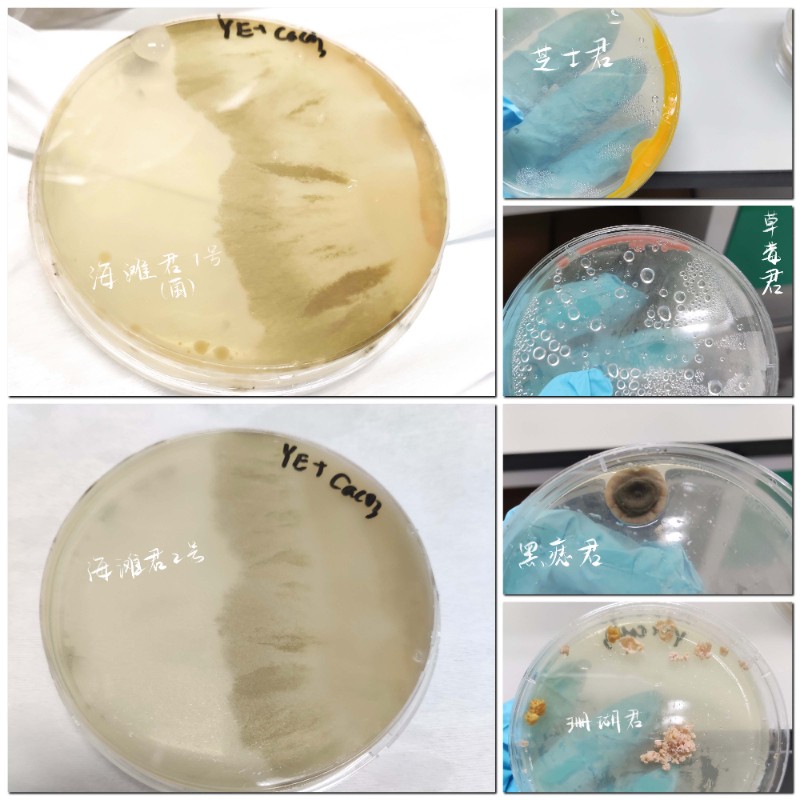
6380015400470453763460862

Ðû²¼ÈÕÆÚ£º£º9/16/2022
ÏÄÈÕµÄÓàÈÈÒ»µãµãɢȥ
Ç^ѧÆÚµÄ½Å²½Öð½¥ÁÚ½ü
²»Öª²»¾õÊî¼ÙÒÑ¿¿½üβÉù
¼ÙÆÚ°Ù̬¡¢¡¢¡¢ÉúÑĶàÑù
Åãͬ×ÅÇï·çºÍ²õÃù
ÈÃÎÒÃÇÒ»Æð»ØÊ×
ÄϹ¬NG28¼¯ÍÅÈ˵ÄÊîÆÚ¾«²Ê
¿ÆÑкÍÉúÑÄ£¬ÎÒÒ»¸öÒ²²»ÂäÏÂ
ÁõÈóäÞ
2019¼¶ÉúÎïÊÖÒÕÓëʳÎ﹤³ÌרҵѧÉú
Õâ¸öÊî¼ÙÎÒ¹ýµÃºÜ³ä·ÖºÜ¾«²Ê¡£¡£¿¼ÊÔºó½øÈëʵÑéн׶Σ¬ÔÚÄϹ¬NG28¼¯ÍÅÉúÎïϵ½ÌÊÚYigal AchmonµÄʵÑéÊÒ¾ÙÐÐÐÂÒ»½×¶ÎµÄÊÂÇé¡£¡£ÊµÑéµÄÀú³ÌÓÐʱ»á¸ÐÊÜÓеãËÀ°å£¬ÓÚÊÇÎÒʵÑé×ÅÓÃͼƬÈÕÖ¾¼Í¼ÌìÌìµÄÊÂÇé¡£¡£´ÓһЩÓÐȤµÄ½Ç¶ÈÈ¥¿´£¬ÈÃÖØ¸´µÄÊÂÇé±äµÃÓÐȤ¡£¡£

¿¢ÊÂÕâÒ»½×¶ÎµÄʵÑéºó£¬ÎÒµÚÒ»´Î×Ô¼ºÍýÏëÁËÒ»´ÎÂÃÐС£¡£ÔÚÂÃ;ÖУ¬ÎÒ´ø×ÅÃÃÃ㬵ÚÒ»´Î×Ô¼º¶©Æ±¡¢¡¢¡¢×ø¸ßÌú¡¢¡¢¡¢×øµØÌú¡£¡£Ò»±ßÕÕ¹ËÃÃÃã¬Ò»±ßÃæÁÙÖÖÖÖÍ»·¢×´Ì¬£¬ÔÚÂÃÐÐÖÐÎÒÇÐʵ¸ÐÊܵ½ÁË×Ô¼ºµÄ¿ªÕ¹¡£¡£

¿¢ÊÂÂọ́¬ÊÇʱ¼ä×öµãʳÎïÈ˸Ã×öµÄÊÂÇéÀ²¡£¡£ÓÚÊÇ£¬ÎÒ×îÏÈÌôÕ½ÖÐÊ½ÃæµãÌÒ»¨ËÖºÍÄÌ»ÆÏÚÂ̶¹¸â¡£¡£´ÓÖÆÏÚ×îÏÈÀú¾ÖØÖØÌôÕ½£¬ÔÚÀֳɵÄÄÇÒ»¿Ì¸ÐÊÜ×Ô¼ºÊÇÈ«ÌìÏÂ×î°ôµÄáÌ¡£¡£


³ýÁËÃÀʳÌôÕ½ÉÐÓлæ»ÉϵÄÐÂʵÑé¡£¡£ÖðÈձŷ¢µÄÐÂÁé¸Ð£¬ÈÃÎÒʵÑéÁË°Ù±ä»·ç£¬ÖÆ×÷ÁËÁ½Ì×΢ÐÅÐÄÇé°ü£¬Íê³ÉÁËÍÏÍÏí³ÀÁ½¸öÔµÄÌõÂþ£¬ÊµÑéÁËеĺñÍ¿·½Ê½£¬»ÁËÖª×ãµÄÖÐÇïÎ÷ϯ½ÚºØÍ¼¡£¡£

ÍØÕ¹ÐËȤϲ»¶£¬·¢Ã÷δÀ´¸ü¶à¿ÉÄÜ
ÂÀ¿¡²ý
2020¼¶ÊýѧÓëÅÌËã»ú¿ÆÑ§×¨ÒµÑ§Éú
ÄϹ¬NG28¼¯ÍÅProtegoÍøÂçÇå¾²×¼±¸ÉçÊ×´´ÈËÖ®Ò»
ÔÚÕâ¸ö¼ÙÆÚ£¬ÎÒ¼ÓÈëÁËÓÉInForSecºÍ¶«ÄÏ´óÑ§ÍøÂç¿Õ¼äÇ徲ѧԺÅäºÏÖ÷ÀíµÄ2022Äê¡°ÍøÂç¿Õ¼äÇå¾²ÏÄÁîÓª¡±£¬ºÍÀ´×Ô61ËùÃûУµÄͬÑâÒ»Æð£¬Ì½Ë÷Õâ¸öÁìÓòµÄ÷ÈÁ¦¡£¡£
Õâ¸öÏÄÁîÓª¹²·ÖÎªÍøÂçÇå¾²ºÍϵͳÇå¾²Á½¸ö°à¼¶£¬ÎÒÃÇËùÊôµÄÍøÂçÇå¾²°à¶àÎªÍø°²µÄ±¾¿ÆÉú¼°CTF£¨¼´ÍøÂçÇå¾²ÁìÓòÖÐÍøÂçÇå¾²ÊÖÒÕÖ°Ô±Ö®¼äµÄÊÖÒÕ¾º¼¼½ÇÖð£©Õ½¶ÓµÄÑ¡ÊÖ£¬ÏµÍ³°àÔòÒÔÍø°²´ÓÒµÕß¼°Ñо¿ÉúΪÖ÷¡£¡£ÕⳡÏÄÁîÓªµÄ½²Ê¦²½¶Óǿʢ£¬º¸ÇCTFÕ½¶Ó¶Ó³¤ºÍÑо¿Ëù²©µ¼¡£¡£½áÓªÈüºó»¹Ô¼ÇëÁ˸ßУ½ÌÊÚ¡¢¡¢¡¢Ïà¹ØÑ§ÔºµÄÔº³¤×÷ÍøÂçÇå¾²Ç°ÑØ¿ÆÑб¨¸æ£¬ÈÃÎÒ¼ûʶµ½ÓëͬÁäÈ˲î±ðµÄͬʱҲʹÎÒÊÜÒæ·Ëdz¡£¡£

Õâ´ÎÏÄÁîÓªÈÃÎÒÏàʶÁËһЩCTFÁªºÏÕ½¶Ó¼°¸ßУµÄÍø°²ÉçÍÅ£¬ÆäÖÐÓгÁµíÏÂÀ´µÄÀÏÅÆÍŶÓÒ²ÓдÓÁã×îÏȵÄÐÂÉúºÚÂí£¬ºÍËûÃǵÄÏàͬ¹´ÆðÁËÎÒ×é½¨Íø°²ÉçÍŵÄÄîÍ·¡£¡£
»Øµ½ÄϹ¬NG28¼¯Íźó£¬ÎÒÃDZ㿪չÁËΪÆÚÈýÖܵÄCTFÈëÃÅÅàѵ£¬ÀֳɾÙÐÐÁ˵ÚÒ»´ÎУÄÚÈü£¬ÎüÒýÁËÒ»Åú¶ÔÍøÂçÇå¾²¸ÐÐËȤµÄÐÂÉú¡£¡£´Ó²ß»®Ðû´«¡¢¡¢¡¢±¸¿Î³öÌâ¡¢¡¢¡¢´î½¨°Ð³¡µ½½áÓª°ä½±£¬Àë²»¿ªÐ£Ïòµ¼ºÍIT²¿·ÖµÄ´óÁ¦Ö§³ÖÒÔ¼°¶ÓÔ±ÃǵÄÎÞ˽֧¸¶¡£¡£

×÷ΪÊýѧÓëÅÌËã»ú¿ÆÑ§×¨ÒµµÄѧÉú£¬ÍøÂçÇå¾²ÉçÍÅÄܸøÎÒÃÇ´øÀ´¸ü¶àµÄʵ¼ùʱ»ú£¬Ò²ÄܸüºÃµØÌá¸ß¶ÔÏà¹ØÆ«Ïò¸ÐÐËȤͬÑâµÄ¾ÍÒµÄÜÁ¦¼°ÉêÑÐÓÅÊÆ¡£¡£×îºó£¬½Ó´ýËùÓжÔÍø°²Æ«ÏòÓÐÐËȤµÄͬÑâ¼ÓÈëÄϹ¬NG28¼¯ÍÅ£¡£¡£¡
ÏíÊÜÂýÉúÑÄ£¬Ñ°ÕÒ¿ìÀÖµÄÖÖ×Ó
ÁºÌìÔó
2020¼¶ÉúÎïÊÖÒÕÓëʳÎ﹤³ÌרҵѧÉú
¹ØÓÚÏíÊÜÉúÑĵÄÈËÀ´Ëµ£¬ÊîÆÚµÄ¸ßβ¢²»¿É×èµ²ËûÃÇ·¢Ã÷ÃÀµÄÑÛ¾¦£º£ºÓêºóµÄ¶Öé»®¹ýÒ¶Ãæ£¬ÁÖÒñÏÂÆÜÏ¢µÄÄñ¶ù£¬Ð±ÑôÓ³ÉäÏµĺ£±ß£¬ÏÊζµÄ²è²ÍÌüÒÔ¼°µÇÉϸßÂ¥Ô¶Ì÷ÉîÛÚÍå´óÇÅ¡£¡£



ÐмÑÄÝ
2020¼¶ÉúÎïÊÖÒÕÓëʳÎ﹤³ÌרҵѧÉú
Êî¼Ù»Ø¼ÒÒÔΪÕû¸öÈ˵ĽÚ×à¶¼ÂýÁËÏÂÀ´£¬¸ú¹·¹·Ò»ÆðÈ¥ºþ±ßÉ¢²½£¬»Ø¼Ò³ÔÂèÂè×öµÄ²Ë£¬ÖØÊ°ÏÐÖÃÁËÁ¼¾ÃµÄ»±Ê£¬Ô¼ÉÏÖ¿ÓÑÒ»Æð¸ú¹ã³¡ÎèÒÌÂèѧÎ赸¡¡Ð¡Ê±¼ä˾¿Õ¼û¹ßµÄСÊÂÏÖÔÚ×öÆðÀ´ÒÔÎªÌØÊ⿪ÐÄ¡£¡£



ÀîÀÖì÷
2022¼¶ÉúÎïÊÖÒÕÓëʳÎ﹤³Ìרҵ
¸ß¿¼¿¢Êºó£¬Ã»µÈЧ¹ûÐû²¼£¬ÎÒ±ãËæ¼ÒÈËÈ¥´óÃÀн®æÒÏ·¡£¡£ÔÚÇåÔçµÄº®·çÖУ¬ÎÒ¿´µ½³¿¹âÁýÕÖϵĺÌľ´å£»£»ÔÚÁÉÀ«µÄ¿¦À¾þ£¬ÎÒ¼ûµ½´«ËµÖеľÅÇúÊ®°ËÍ䣻£»ÔÚÌÒÔ°°ãµÄ¿¦ÄÉ˹£¬ÎÒÍû¼ûÔ¶´¦µÄѩɽÓëÑÛǰµÄСºÓ¡£¡£



̤ÉϼÌÐøÉîÔìµÄÂọ́¬ÔÚÒì¹úÒìÏçÓö¼û¸üºÃµÄ×Ô¼º
ÕÅÃÎÇï
2018¼¶»¯Ñ§¹¤³Ìרҵ½áÒµÉú
ǰÍùºÉÀ¼°¢Ä·Ë¹Ìص¤¹¥¶Á˶ʿ¿Î³Ì
Õâ¸öÑ×Ì죬ÎÒ´ÓÄϹ¬NG28¼¯ÍÅ˳Ëì½áÒµÀ²¡£¡£°´Á÷³ÌÒ»²½²½°ìÍêÊÖÐø£¬ÎÒÍÑÀëÊìϤµÄÍÁµØ£¬Ì¤ÉÏÈ¥ÍùºÉÀ¼¼ÌÐøÉîÔìµÄÂó̡£¡£
Ëä¶ÀÔÚÒìÏ磬µ«ÎÒÓöµ½ÁËÐí¶àÎÂůµÄÈË¡£¡£ÔÚÕâÀ¸÷ÈËËÆºõ»áÔ½·¢¾ø²»ÑÚÊεرí´ï¶Ô±ðÈ˵Äϲ»¶ºÍä¯ÀÀ¡£¡£Éí´¦Õâ¸ö¿É°®µÄ¡°»¨»ÜÖ®¹ú¡±£¬ÎÒÃǶ¼ÔÚÓÃÓïÑÔºÍÐж¯ÎÂů×ÅÏ໥¡£¡£

ÕâÕÅͼÊÇÎÒ¸Õ¿ªÑ§Ê±¸ú×øÔÚÎÒÉí±ßÅ®ÉúµÄ¶Ô»°¡£¡£¡£¡£¡°Ã»ÓÐÈËÓ¦¸ÃÂäµ¥¡£¡£ÎÒÒÔΪÄãÊÇÒ»¸ö³¬µÈºÃµÄÈË£¬ÎÒͬÑùÒ²ÏíÊÜÄãµÄÅãͬ¡£¡£¡£¡£¡°Õâ¾ä»°ÎÂůÁËÆäʱÒÔΪ¹Â¿àµÄÎÒ£¬ÎÒ×îÏÈÔ½·¢ÆÚ´ýδÀ´µÄÖÖÖÖÌôÕ½¡£¡£

ÔÚwaterlooplein¼¯ÊеÄÓô½ðÏã̯λÅÔ£¬ÎÒÒ²ÐËÆðÓÂÆø£¬ÔÞÃÀÁËһλºÜÓÐÆøÖʵÄÄÌÄÌ¡£¡£ÔÙ´ÎżÓöʱ£¬ÎÒÃÇ»¹Ò»ÆðÅÄÁ˺ÏÓ°¡£¡£ÄÇλÄÌÄÌ˵ÎҵĿ佱made her day£¨ÈÃËýµÄÒ»Ìì¶¼ºÜÓä¿ì£©£¬¶øËý¸øÎҵĻØÓ¦Ò²ËƺõÓÐħÁ¦Ò»°ã£¬ÈÃÎÒµÄÐÄÇéºÃÁËÆðÀ´¡£¡£
ÎÒÒÔΪ£¬±í´ï×Ô¼ºµÄϲ»¶ºÍä¯ÀÀ²»ÊÇʲôÄÑÌâµÄÊ£¬¿ÉÄÜÒÔǰϰ¹ßÁËÔ̽壬µ«Ò»µ©ÄãÂõ³öÁ˵ÚÒ»²½£¬Äã»á×îÏÈÏíÊÜÕâ¸öÀú³Ì¡£¡£

»ÆÐÀâù
2017¼¶»¯Ñ§¹¤³Ìרҵ½áÒµÉú
ǰÍùÈðÊ¿ÂåÉ£¹¥¶Á˶ʿ¿Î³Ì
Õâ¸öÊî¼Ù£¬ÊÇÊôÓÚÄϹ¬NG28¼¯ÍŵÄÊî¼Ù£¬¿ì»îµÃÇ¡ËÆÒª¹ýÄê¡£¡£ÎÒµÄÊÒÓÑÀîÒÀU£¨ÄϹ¬NG28¼¯Ížý×¢£º£º2017¼¶ÉúÎïÊÖÒÕÓëʳÎ﹤³Ìרҵ½áÒµÉú£©£¬»¹Ã»¿ªÑ§£¬¾Í´ÓºÉÀ¼ºÍÒÝ·²£¨ÄϹ¬NG28¼¯Ížý×¢£º£º2017¼¶»¯Ñ§¹¤³Ìרҵ½áÒµÉú£©¼±¼±åáµ½ÂåÉ£ÂÃÐÐÎҵļң¬Æ·³¢ÍâµØÃÀʳ¡£¡£ËûÃÇ»¹ÏñÒÔǰÄÇÑùÓ¸ÒÎÞ磬ÎÒÃÇ´Óδ¸Ä±ä¡£¡£


¸Õ¸ÕËÍ×ß´ÓºÉÀ¼À´µÄÅóÙ£¬ÓÖÓÀ´ÁËÓ¢¹úµÄ¿ÍÈË¡£¡£ÖÂŵ£¨ÄϹ¬NG28¼¯Ížý×¢£º£º2017¼¶»¯Ñ§¹¤³Ìרҵ½áÒµÉú£©Ò²À´ÕÒÔÚÈðÊ¿×ö½»Á÷ÉúµÄÓ½·å£¨ÄϹ¬NG28¼¯Ížý×¢£º£º2017¼¶»¯Ñ§¹¤³Ìרҵ½áÒµÉú£©ÍæÀ²¡£¡£¾ÍÔÚÎÒ¼±åá×øµç³µÓëËûÃÇ»áʦµÄʱ¼ä£¬Óöµ½ÁËÈý¸öÊìϤµÄÃæÄ¿¡£¡£°¡£¡£¬Õâ²»ÊǺ¼ÁØ£¨ÄϹ¬NG28¼¯Ížý×¢£º£º2017¼¶ÖÊÁÏ¿ÆÑ§Ó빤³Ìרҵ½áÒµÉú£©µÄÇ×ʦµÜÃÇÂï¡£¡£Õâ¸öÊî¼Ù£¬ÄϹ¬NG28¼¯ÍÅŨ¶È100%£¡£¡£¡

¿ìÀֵķ½Ê½¶àÖÖ¶àÑù
ÓÅÃÀµÄ¼ÙÆÚ¸÷Óвî±ð
ÏÂÆÚʵϰʵ¼ùƪ
½«´øÄã½âËø¸ü¶à
ÄϹ¬NG28¼¯ÍÅÈ˵ijä·ÖÊîÆÚ
© ÄϹ¬NG28¼¯ÍÅ °æÈ¨ËùÓÐ | ÔÁICP±¸17036470ºÅ